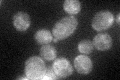
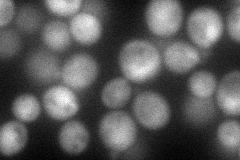
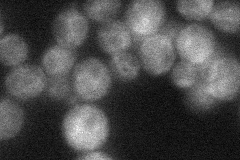
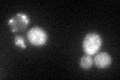
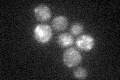

View description
Peripheral membrane protein needed for Golgi-to-ER retrograde traffic; forms a complex with Sec39p and Tip20p that interacts with ER SNAREs Sec20p and Use1p; component of the ER target site that interacts with coatomer; interacts with Cin5p
Localization:
Intensity:
Fold change:
Significance:
-
C’ GFP library in SD
ER31.17 -
N' NOP1pr-GFP in SD

cytosol62.9354 -
N' TEF2pr-mCherry in SD
cytosol,nucleus79.4847 -
N' NATIVEpr-GFP in SD
ER30.9948 -
N' TEF2pr-VC and Cyto-VN in SD

cytosol31.2872 -
C’ GFP library in SD+DTT
ER38.871.24No -
C’ GFP library in SD+H2O2

ER34.281.09No -
C’ GFP library in Starvation Media
ER27.740.88No -
C’ GFP library on the background of Pup2-DaMP

ER -
C’ GFP library on the background of CCT mutant

ER30.88550.99048No
